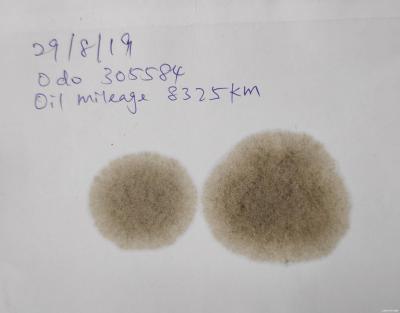
Attached Image

QUOTE(90Boyz @ Aug 26 2019, 10:07 AM)

Upload on behalf of a friends of mine wish to know the condition of the oil
Mercedes Benz S600 6.0 V12 year 1994
Bought over from owner and previously car sit in the garage over a year before tow back to workshop for repair and service
Oil use : Shell Helix HX3 20w50
Oil mileage: roughly 400Km
Odo meter : unknown as meter spoiled
This 1994 MB S600 6.0L V12 is a
W140 carrying an
M120 engine with port fuel injection system.
A bit of history , back in USA the API SH (obsolete) was launched in 1993 whilst SJ was launched in 1996.
In Malaysia ,this MB S600 would have called for SH (which wasn't available in Malaysia until probably 1995/1996) or SG which was available beyond 1994.
Recommended OCI (oil change interval in km) back then had always been 5,000 km for our local petrol with sulphur content of around 10,000 or more ppm (parts per million of Sulphur in petrol) .
However, this MB S600 was likely imported European version into Malaysia as used car.
In Europe, it likely called for European spec CCMC G4 or G5 petrol engine oils whose specs is over and above that of API SH.
This engine probably called for similar oci of 5,000 km with pre-Euro 1 petrol of sulphur content around 5,000 ppm in Europe then.
Now, this Shell HX3 20W50 API SL far exceeds the original API SG/SH specifications requirements of MB back in 1994 and bearing in mind that currently available Malaysian petrol is more superior and cleaner at Euro II (500 ppm Sulphur) or Euro VI (50 ppm sulphur) petroleum standards, I'm of the opinion its oil change interval OCI should be good for 5000 km or likely more, assuming a reasonably maintained engine condition.
Now, coming back to your blotter spot.
In relations to other blotter spot pictures at Post #1 , this 400 km usage HX3 20W50 engine oil is a bit on the 'dirty' side as demonstrated by its darker shades of soot/byproducts of combustion and oxidation within the intermediate diffusion zone.
Is it due to poor engine oil quality or 'dirty' engine internals ? IDK for now but it likely could be both, who knows.
However upcoming blotter spot tests on this oil probably could tell us something more as we progress from here .
The good news now is that the dirt/byproducts/soot is of small size, small quantity and light enough to be carried by the oil far away from the centre/deposit zone into the external diffusion zone . This indicates oil oxidation is not serious enough and its detergency and dispersancy capabilities are still in tip top condition and hence this used oil is fit for continuing service, IMHO.
It also shows absence of fuel dilution problem , probably all 12 fuel injectors are working normally with a new fuel pump in place. The blotter also shows absence of coolant/glycol problem in the engine.
You may need to check with your friend about his comfortable oil change interval. Assuming a tentative OCI of 5000 km, I wish to suggest taking a blotter spot test at every 1,000 km interval from now on for evaluation/comparison of used oil conditions , until say km 4000/4500 with a view of making a final decision then whether to proceed with replacement of this HX3 20W50 sample at 5,000 km as intended.
Just my 2 sen.
Edit:Your friend should seriously consider MB-approval oils in future, not oil spec'ed in API only.
This post has been edited by zeng: Aug 27 2019, 03:02 PM 

 Aug 26 2019, 04:55 PM
Aug 26 2019, 04:55 PM

 Quote
Quote

0.0226sec
0.0226sec
 0.38
0.38
 6 queries
6 queries
 GZIP Disabled
GZIP Disabled